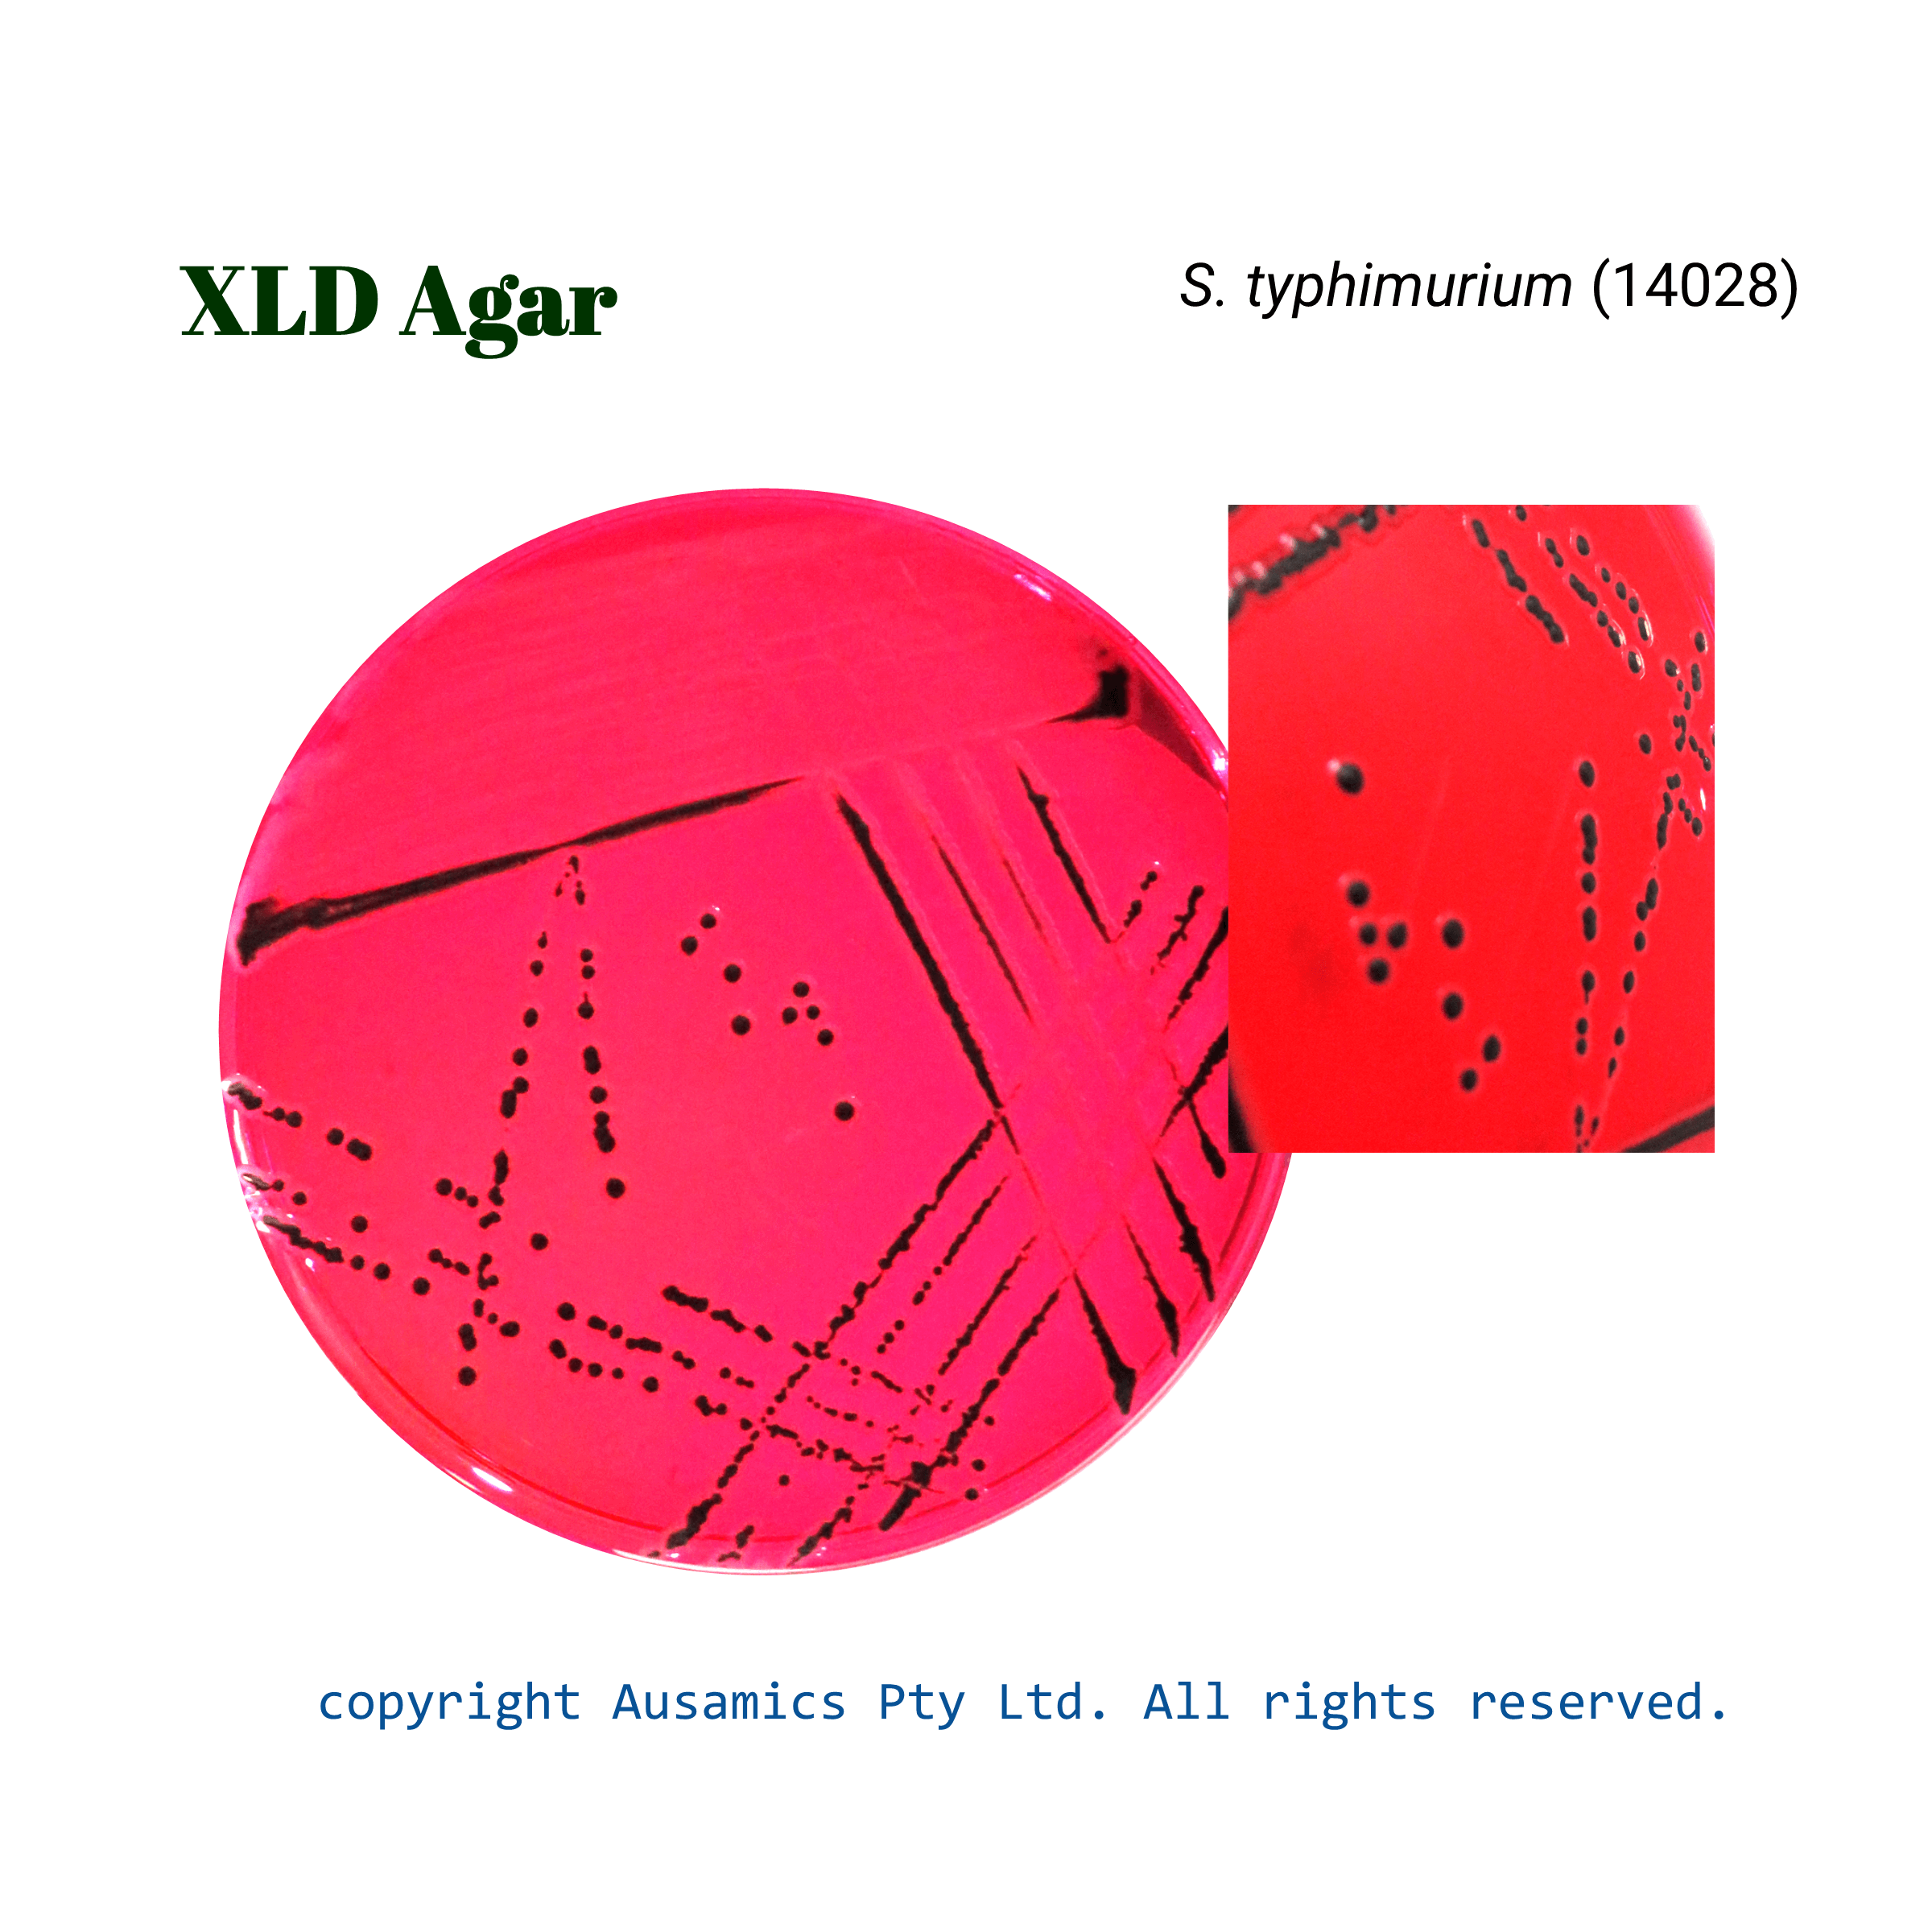
XLD_Styphimurium_(14028)_Ausamics

Xylose Lysine Deoxycholate Agar, XLD
Used for isolating pathogenic Enterobacteria, especially Shigella and Salmonella from biological and food samples.
- Description
- Composition
- Quality Control
- Microbial Test Results
Salmonella species are isolated and presumed to be identified using Xylose Lysine Deoxycholate (XLD) agar, a selective and differential culture medium. Deoxycholate is added to the medium as a selective agent to inhibit the growth of some Gram-negative bacteria and Gram-positive organisms.
XLD agar differentiates between enteric bacteria using a range of biochemical characteristics. Fermentable carbohydrates include xylose, lactose, and sucrose, lysine acts as a substrate for the decarboxylation. To produce hydrogen sulfide, ferric ammonium citrate and sodium thiosulfate are added. Phenol red serves as a pH indicator.
Most salmonella species quickly ferment xylose, generating acid and coloring medium yellow. But later lysine decarboxylation raises the pH, which brings about an alkaline condition again. Black-centered colonies may emerge because of hydrogen sulfide generation in these alkaline conditions. The putative identification of Salmonella is aided by these distinctive colony morphologies
Storage
Keep the container at 15-30 °C and prepared medium at 2-8 °C.
| Composition | gr/L |
| Xylose | 3.5 |
| Lactose | 7.5 |
| L-Lysine | 5 |
| Sucrose | 7.5 |
| Yeast Extract | 3 |
| Sodium Thiosulphate | 6.8 |
| Sodium Chloride | 5 |
| Sodium Deoxycholate | 2 |
| Phenol Red | 0.08 |
| Ferric Ammonium Citrate | 0.8 |
| Agar | 12 |
| Final pH at 25°C | 7.4 ± 0.2 |
| Dehydrated Appearance | Pink, free-flowing, homogeneous. |
| Prepared Appearance | Pale red, slightly opalescent. |
| Reaction of 5.3% Solution at 25°C | pH 7.4 ± 0.2 |
| Incubate at 35 ± 2 °C for 18 to 24 hours. Incubate cultures (**) at 30 to 35°C for 18 to 48 hours and cultures (***) at 35 to 37°C for 18 to 72 hours. | ||
| Organism (ATCC) | Recovery | Colony color |
| Escherichia coli (25922) | Partial inhibition | Yellow |
| Escherichia coli** (8739) | Partial to complete inhibition (30-35°C) | Yellow |
| Enterococcus faecalis (29212) | Partial inhibition | – |
| Salmonella enterica** (14028) | Growth (30-35°C) | Red with black centers |
| Salmonella enterica*** (14028) | Growth (35-37°C) | Red with black centers |